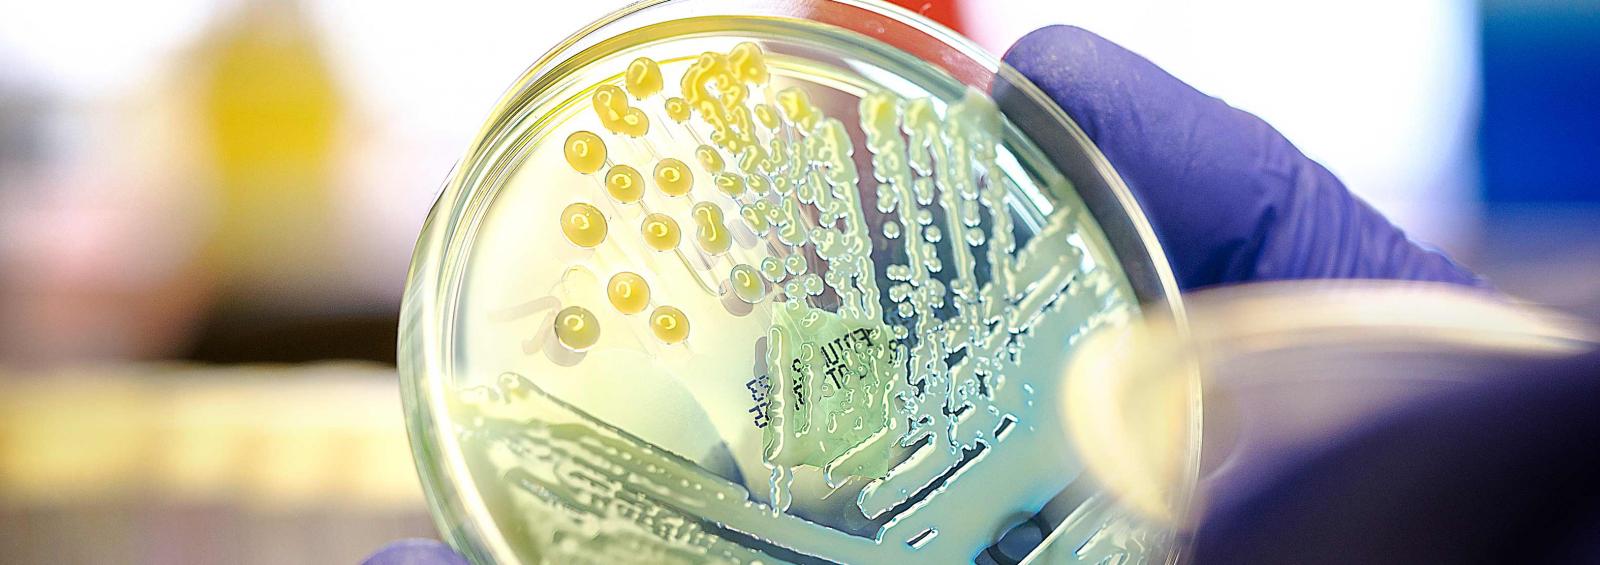

Schneider Lab
Investigators in the Schneider Lab at NYU Langone conduct research in two areas. The first research program studies the development, progression, and metastasis of breast cancer, the interplay of the inflammatory response in human cancer, and the development of new clinical therapeutics and clinical trials based on this work. This research effort aims to advance the molecular and genetic understanding of advanced breast cancers.
Much of this research is focused on the molecular basis of locally advanced and inflammatory breast cancers and their progression to metastatic disease, particularly the major role of translational regulation in these processes. We investigate the specific alterations in the mTOR signal transduction pathway, translation factor alterations, and microRNAs in human breast cancer, which informs our translational and clinical research and development of novel clinical trials. Our research has played a significant role in the development of small molecule inhibitors of selective oncogenic mRNA translation, one of which is in phase 2 clinical trials.
Our second research program is focused on a molecular understanding of gene regulation by targeted accelerated mRNA decay, particularly in inflammatory cytokine expression controlled by the gene AUF1. This research involves the numerous intersections of control of rapid mRNA decay with human disease and exposure to radiation, including cancer, inflammatory disorders, and accelerated aging.
In both major project areas, we develop animal models of human disease.
Contact Us
Robert J. Schneider, PhD
The Albert B. Sabin Professor of Microbiology and Molecular Pathogenesis, Department of Microbiology
Professor, Department of Radiation Oncology
Co-director, Breast Cancer Research Program
Alexandria Center for Life Science – East Tower
450 East 29th Street, Third Floor
New York, NY 10016
Office Phone: 212-263-6006
Fax: 646-501-4541